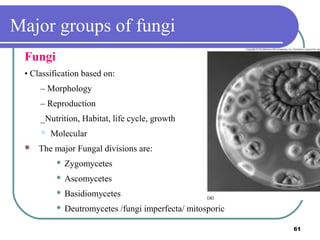
Major groups of fungi
Fungi
• Classification based on:
– Morphology
– Reproduction
_Nutrition, Habitat, life cycle, growth




Molecular

The major Fungal divisions are:


Zygomycetes



Ascomycetes



Basidiomycetes



Deutromycetes /fungi imperfecta/ mitosporic
61

This document provides an overview of a microbiology course. It outlines the course objectives, which include describing various microorganisms like bacteria, viruses, and parasites. It also covers classifying microbes, their cellular characteristics, and the differences between eukaryotes and prokaryotes. The document discusses the historical development of microbiology from early microscope observations to modern techniques and discoveries. Key figures that advanced the field include van Leeuwenhoek, Hooke, Pasteur, Koch, and Fleming.












































![1877
Robert Koch develops methods for staining bacteria, photographing, and preparing
permanent visual records on slides.
1881
Koch develops solid culture media and the methods for obtaining pure cultures of bacteria.
1882
Angelina Fannie and Walther Hesse in Koch's laboratory develop the use of agar as a
support medium for solid culture.
1884
Hans Christian Gram develops a dye system for identifying bacteria [the Gram stain].
1887
First report of the petri plate by Julius R. Petri.
1915
M. H. McCrady establishes a quantitative approach for analyzing water samples using the
most probable number, multiple-tube fermentation test.
45](https://image.slidesharecdn.com/micro-part1-131204143522-phpapp01/85/introduction-to-Microbiology-45-320.jpg)